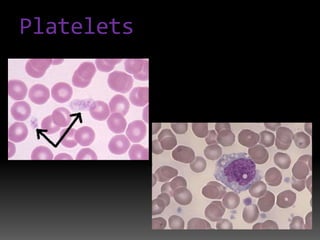
Platelets

The circulatory system transports blood, nutrients, gases, and waste throughout the body via blood vessels and the heart. It is composed of the cardiovascular system including the heart, which pumps blood, and blood vessels. The heart has four chambers that receive and pump blood into and out of the lungs and body. Blood contains red blood cells, white blood cells, and platelets and carries oxygen, nutrients, hormones, and removes waste. It flows through arteries, capillaries, and veins.